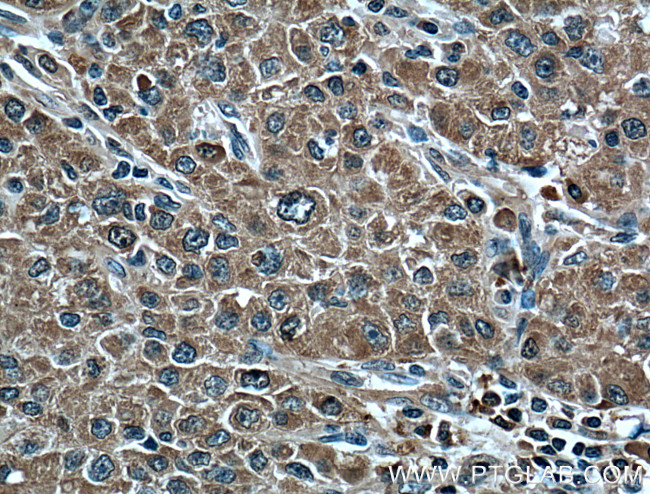
Plasminogen Antibody in Immunohistochemistry (Paraffin) (IHC (P))

Search
Proteintech
Plasminogen Monoclonal Antibody (1F6A11)
{{$productOrderCtrl.translations['antibody.pdp.commerceCard.promotion.promotions']}}
{{$productOrderCtrl.translations['antibody.pdp.commerceCard.promotion.viewpromo']}}
{{$productOrderCtrl.translations['antibody.pdp.commerceCard.promotion.promocode']}}: {{promo.promoCode}} {{promo.promoTitle}} {{promo.promoDescription}}. {{$productOrderCtrl.translations['antibody.pdp.commerceCard.promotion.learnmore']}}
产品信息
66399-1-IG
种属反应
宿主/亚型
分类
类型
克隆号
抗原
偶联物
形式
浓度
规格
纯化类型
保存液
内含物
保存条件
运输条件
产品详细信息
Immunogen sequence: VVAPPPVVL LPDVETPSEE DCMFGNGKGY RGKRATTVTG TPCQDWAAQE PHRHSIFTPE TNPRAGLEKN YCRNPDGDVG GPWCYTTNPR KLYDYCDVPQ CAAPSFDCGK PQVEPKKCPG RVVGGCVAHP HSWPWQVSLR TRFGMHFCGG TLISPEWVLT AAHCLEKSPR PSSYKVILGA HQEVNLEPHV QEIEVSRLFL EPTRKDIALL KLSSPADITD KVIPACLPSP NYVVADRTEC FITGWGETQG TFGAGLLKEA QLPVIENKVC NRYEFLNGRV QSTELCAGHL AGGTDSCQGD SGGPLVCFEK DKYILQGVTS WGLGCARPNK PGVYVRVSRF VTWIEGVMRN N (461-810 aa encoded by BC060513)
靶标信息
Plasminogen is a plasma protein synthesized mostly in the liver. It consists of a single polypeptide chain and has a molecular weight of 88.5 kDa. The plasma concentration is usually in the range of 70 - 200 mg/L. Plasminogen is activated by tissue-plasminogen activator, urokinase and streptokinase, to form plasmin. Activation results from the cleavage and release of the preactivation peptide. Plasmin consists of a heavy (A-) chain which contains 5 kringles and a light (B-) chain with the active site. Plasmin is a trypsin-like protease whose natural substrate is fibrin, with binding sites for fibrin residing on the kringles. Plasmin is essential for fibrinolysis and decreased fibrinolytic potential due to congenital defects in plasmin can lead to recurring thrombosis, thrombophlebitis and pulmonary embolism.
仅用于科研。不用于诊断过程。未经明确授权不得转售。
生物信息学
蛋白别名: DKFZp779M0222; plasmin; Plasminogen; RP1-81D8.1; unnamed protein product
基因别名: HAE4; PLG
UniProt ID: (Human) P00747
Entrez Gene ID: (Human) 5340